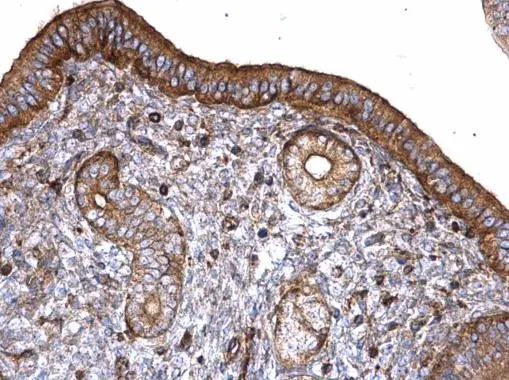
T-Plastin antibody detects T-Plastin protein at cytoplasm on mouse cervix by immunohistochemical analysis. Sample: Paraffin-embedded mouse cervix. T-Plastin antibody (GTX103323) diluted at 1:500. 
 Antigen Retrieval: Trilogy? (EDTA based, pH 8.0) buffer, 15min

Sample (30 μg of whole cell lysate) A: NIH-3T3 B: JC C: BCL-1 7.5% SDS PAGE GTX103323 diluted at 1:1000 The HRP-conjugated anti-rabbit IgG antibody (GTX213110-01) was used to detect the primary antibody.
T-Plastin antibody
GTX103323
ApplicationsImmunoFluorescence, Western Blot, ImmunoCytoChemistry, ImmunoHistoChemistry, ImmunoHistoChemistry Paraffin
Product group Antibodies
ReactivityHuman, Mouse
TargetPLS3
Overview
- SupplierGeneTex
- Product NameT-Plastin antibody
- Delivery Days Customer9
- Application Supplier NoteWB: 1:500-1:10000. ICC/IF: 1:100-1:1000. IHC-P: 1:100-1:1000. *Optimal dilutions/concentrations should be determined by the researcher.Not tested in other applications.
- ApplicationsImmunoFluorescence, Western Blot, ImmunoCytoChemistry, ImmunoHistoChemistry, ImmunoHistoChemistry Paraffin
- CertificationResearch Use Only
- ClonalityPolyclonal
- Concentration0.23 mg/ml
- ConjugateUnconjugated
- Gene ID5358
- Target namePLS3
- Target descriptionplastin 3
- Target synonymsBMND18, DIH5, T-plastin, plastin-3, T fimbrin, T plastin
- HostRabbit
- IsotypeIgG
- Protein IDP13797
- Protein NamePlastin-3
- Scientific DescriptionPlastins are a family of actin-binding proteins that are conserved throughout eukaryote evolution and expressed in most tissues of higher eukaryotes. In humans, two ubiquitous plastin isoforms (L and T) have been identified. Plastin 1 (otherwise known as Fimbrin) is a third distinct plastin isoform which is specifically expressed at high levels in the small intestine. The L isoform is expressed only in hemopoietic cell lineages, while the T isoform has been found in all other normal cells of solid tissues that have replicative potential (fibroblasts, endothelial cells, epithelial cells, melanocytes, etc.). The C-terminal 570 amino acids of the T-plastin and L-plastin proteins are 83% identical. It contains a potential calcium-binding site near the N terminus. Two transcript variants encoding the same protein have been found for this gene. [provided by RefSeq]
- ReactivityHuman, Mouse
- Storage Instruction-20°C or -80°C,2°C to 8°C
- UNSPSC41116161

![T-Plastin antibody detects T-Plastin protein at cytoplasm and nucleus by immunofluorescent analysis. Sample: HeLa cells were fixed in 4% paraformaldehyde at RT for 15 min. Green: T-Plastin protein stained by T-Plastin antibody (GTX103323) diluted at 1:100. Red: alpha Tubulin, a cytoskeleton marker, stained by alpha Tubulin antibody [GT114] (GTX628802) diluted at 1:500. Blue: Hoechst 33342 staining. T-Plastin antibody detects T-Plastin protein at cytoplasm and nucleus by immunofluorescent analysis. Sample: HeLa cells were fixed in 4% paraformaldehyde at RT for 15 min. Green: T-Plastin protein stained by T-Plastin antibody (GTX103323) diluted at 1:100. Red: alpha Tubulin, a cytoskeleton marker, stained by alpha Tubulin antibody [GT114] (GTX628802) diluted at 1:500. Blue: Hoechst 33342 staining.](https://www.genetex.com/upload/website/prouct_img/normal/GTX103323/GTX103323_40205_20150410_IFA_w_23060119_720.webp)







